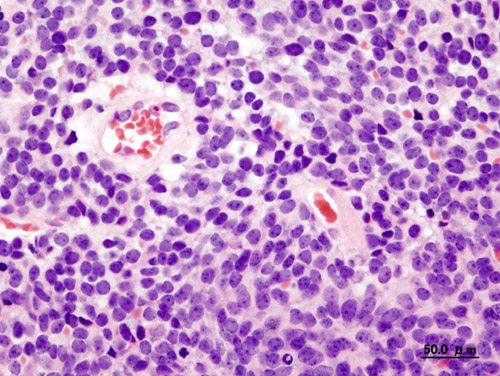
Medulloblastoma

Central Nervous System Tumors Pathology Video
CNS Tumors
Central nervous system (CNS) tumors are abnormal growths that involve the central nervous system.
Types of central nervous system (CNS) tumors include:
- Glioblastoma multiforme (GBM)
- Meningioma
- Schwannoma
- Oligodendroglioma
- Pilocytic astrocytoma
- Medulloblastoma
- Ependymoma
- Craniopharyngioma
Approximately 50 percent of central nervous system (CNS) tumors are metastatic.
Approximately 50 percent of central nervous system (CNS) tumors are primary.
Metastatic tumors to the central nervous system (CNS) typically appear at the gray-white matter junction as a number of distinct lesions.
Common sources of metastasis to the include the kidney, breast, and lung.
Primary central nervous system (CNS) tumors are categorized based on the cell type that has given rise to them which includes:
- Astrocytes
- Meningothelial cells
- Ependymal cells
- Oligodendrocytes
- Neuroectoderm
In adults, primary central nervous system (CNS) tumors are typically supratentorial.
In children, primary central nervous system (CNS) tumors are usually infratentorial.
The three most prevalent central nervous system (CNS) tumors in children are:
- Pilocytic astrocytoma
- Ependymoma
- Medulloblastoma
Primary malignant central nervous system (CNS) tumors rarely metastasize.
Primary malignant central nervous system (CNS) tumors are locally devastating.
Glioblastoma Multiforme (GBM)
Glioblastoma multiforme (GBM) is a malignant, high-grade tumor of astrocytes.
Glioblastoma multiforme (GBM) is the most common primary malignant central nervous system (CNS) tumor in adults.
The cerebral hemisphere is where the “butterfly” lesion associated with glioblastoma multiforme (GBM), which often spans the corpus callosum, develops.
Histologically, glioblastoma multiforme (GBM) tumor cells are glial fibrillary acidic protein (GFAP) positive and are characterized by areas of necrosis surrounded by proliferating endothelial cells.
Glioblastoma multiforme (GBM) has a poor prognosis.
Meningioma
Meningiomas are benign tumors of arachnoid cells.
Meningiomas are the most common benign central nervous system (CNS) tumor in adults.
Meningiomas are more common in females than males.
Meningiomas may cause seizures due to the tumor compressing the cortex without invading it.
Radiology of meningiomas typically show a spherical mass linked to the dura is seen through imaging.
The histology of meningiomas is characterized by a whorled pattern with psammoma bodies.
Schwannoma
Schwannomas are benign tumors of Schwann cells.
Schwannomas may involve spinal or cranial nerves.
In the head, the vestibular cochlear (VIII) nerve at the cerebellopontine angle is most usually involved by schwannomas.
The histology of schwannomas is characterized by spindle cells that are S-100 stain positive.
Bilateral schwannomas are often seen in patients with neurofibromatosis type II (NF2).
Oligodendroglioma
Oligodendrogliomas are malignant tumors of oligodendrocytes.
Radiology of oligodendrogliomas typically show a calcified tumor involving the central nervous system (CNS).
Oligodendrogliomas typically affects the frontal lobe.
Oligodendrogliomas may cause seizures due to mass effect.
Histology of oligodendrogliomas typically show “fried egg” appearing cells that are pathognomonic for this tumor.
Pilocytic Astrocytoma
A pilocytic astrocytoma is a benign tumor of astrocytes.
Pilocytic astrocytomas are the most typical central nervous system tumor in children.
Pilocytic astrocytomas tends to develop in the cerebellum.
Radiology of pilocytic astrocytomas typically show a mural nodule and a cystic lesion are seen on imaging.
Histology of pilocytic astrocytomas shows eosinophilic granular aggregates and Rosenthal fibers (thick eosinophilic processes of the astrocytes).
The tumor cells of pilocytic astrocytomas are glial fibrillary acidic protein (GFAP) positive.
Medulloblastoma
Medulloblastomas are a malignant tumor originating from the cerebellum’s granular cells (neuroectoderm).
Medulloblastomas typically occurs in children.
Medulloblastomas typically grow very rapidly.
The histology of medulloblastomas shows small, rounded blue cells are visible on histology, and Homer-Wright rosettes might be present.
Medulloblastomas are characterized by a poor prognosis.
Ependymoma
Ependymomas are central nervous system tumors composed of malignant ependymal cells.
Ependymomas typically effect children.
Ependymomas most frequently occurs in the fourth ventricle and may be accompanied with hydrocephalus.
Histology of ependymomas classically show perivascular pseudorosettes are seen.
Craniopharyngioma
Craniopharyngiomas are central nervous system tumors that develop from Rathke’s pouch epithelial remnants.
In children or young adults, craniopharyngiomas manifests as a supratentorial mass.
Craniopharyngiomas have the potential to compress the optic chiasm and cause bitemporal hemianopsia.
Radiology of craniopharyngiomas typically shows calcifications.